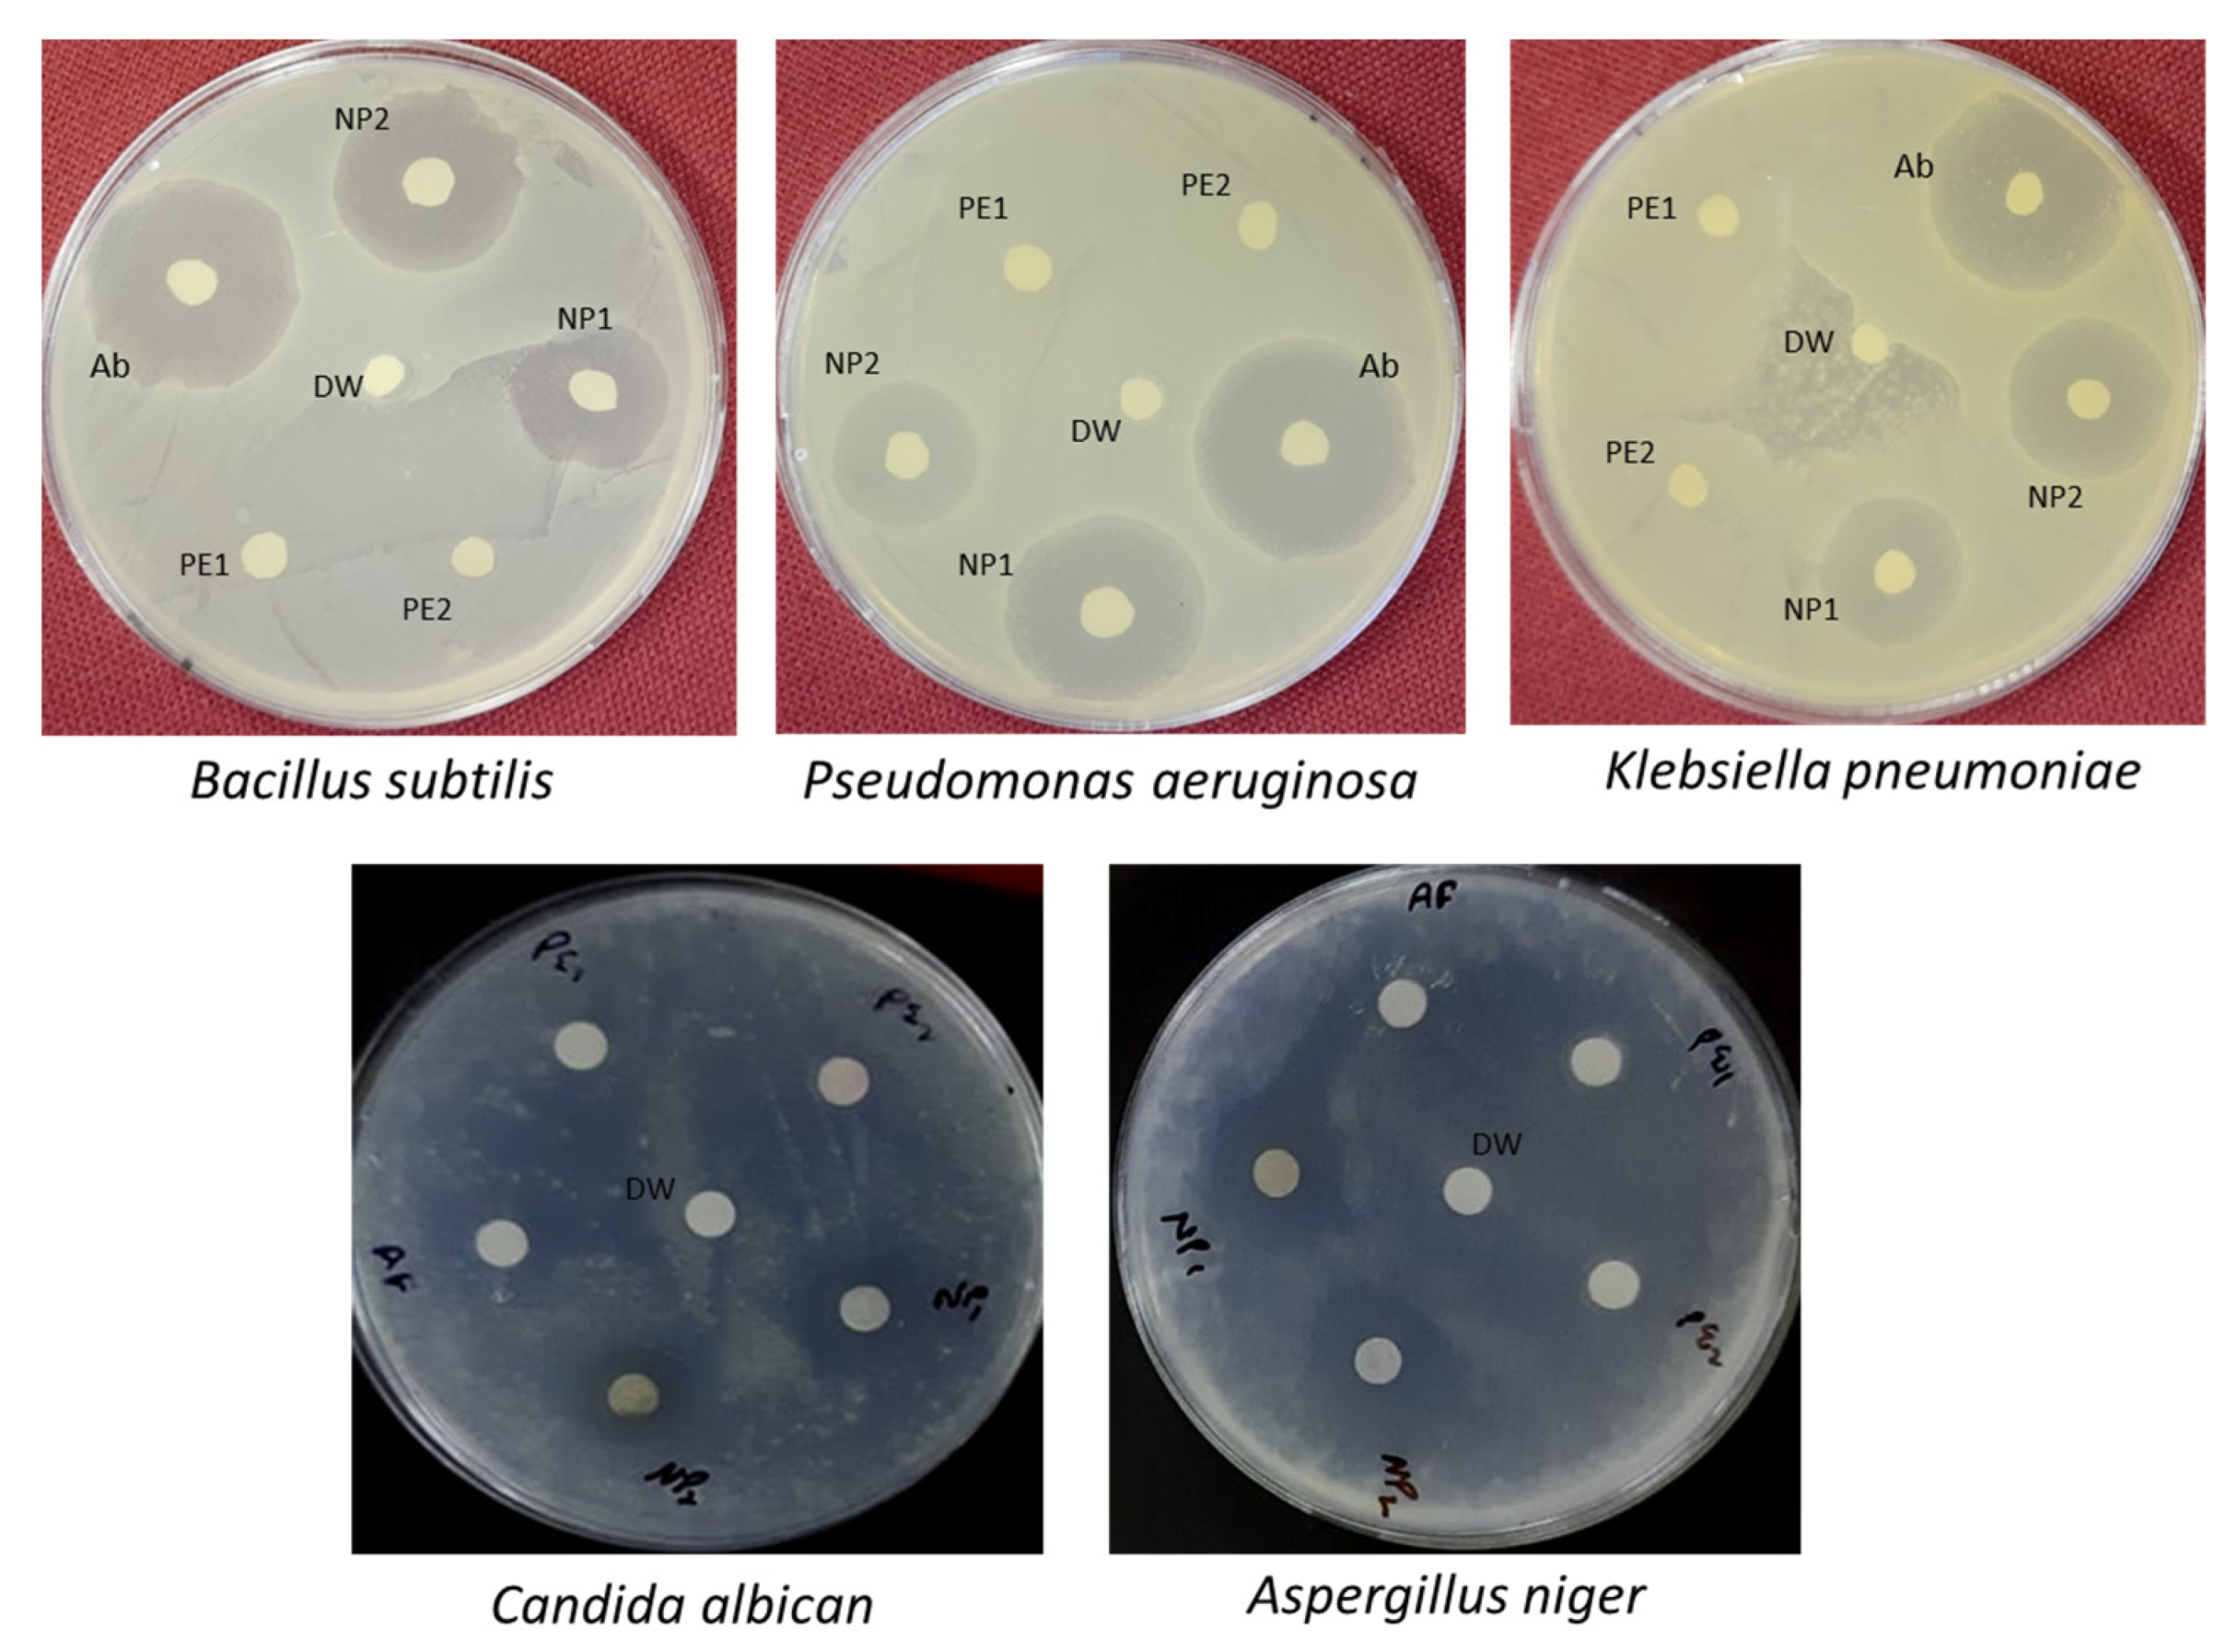
Sustainability 15 08911 g012
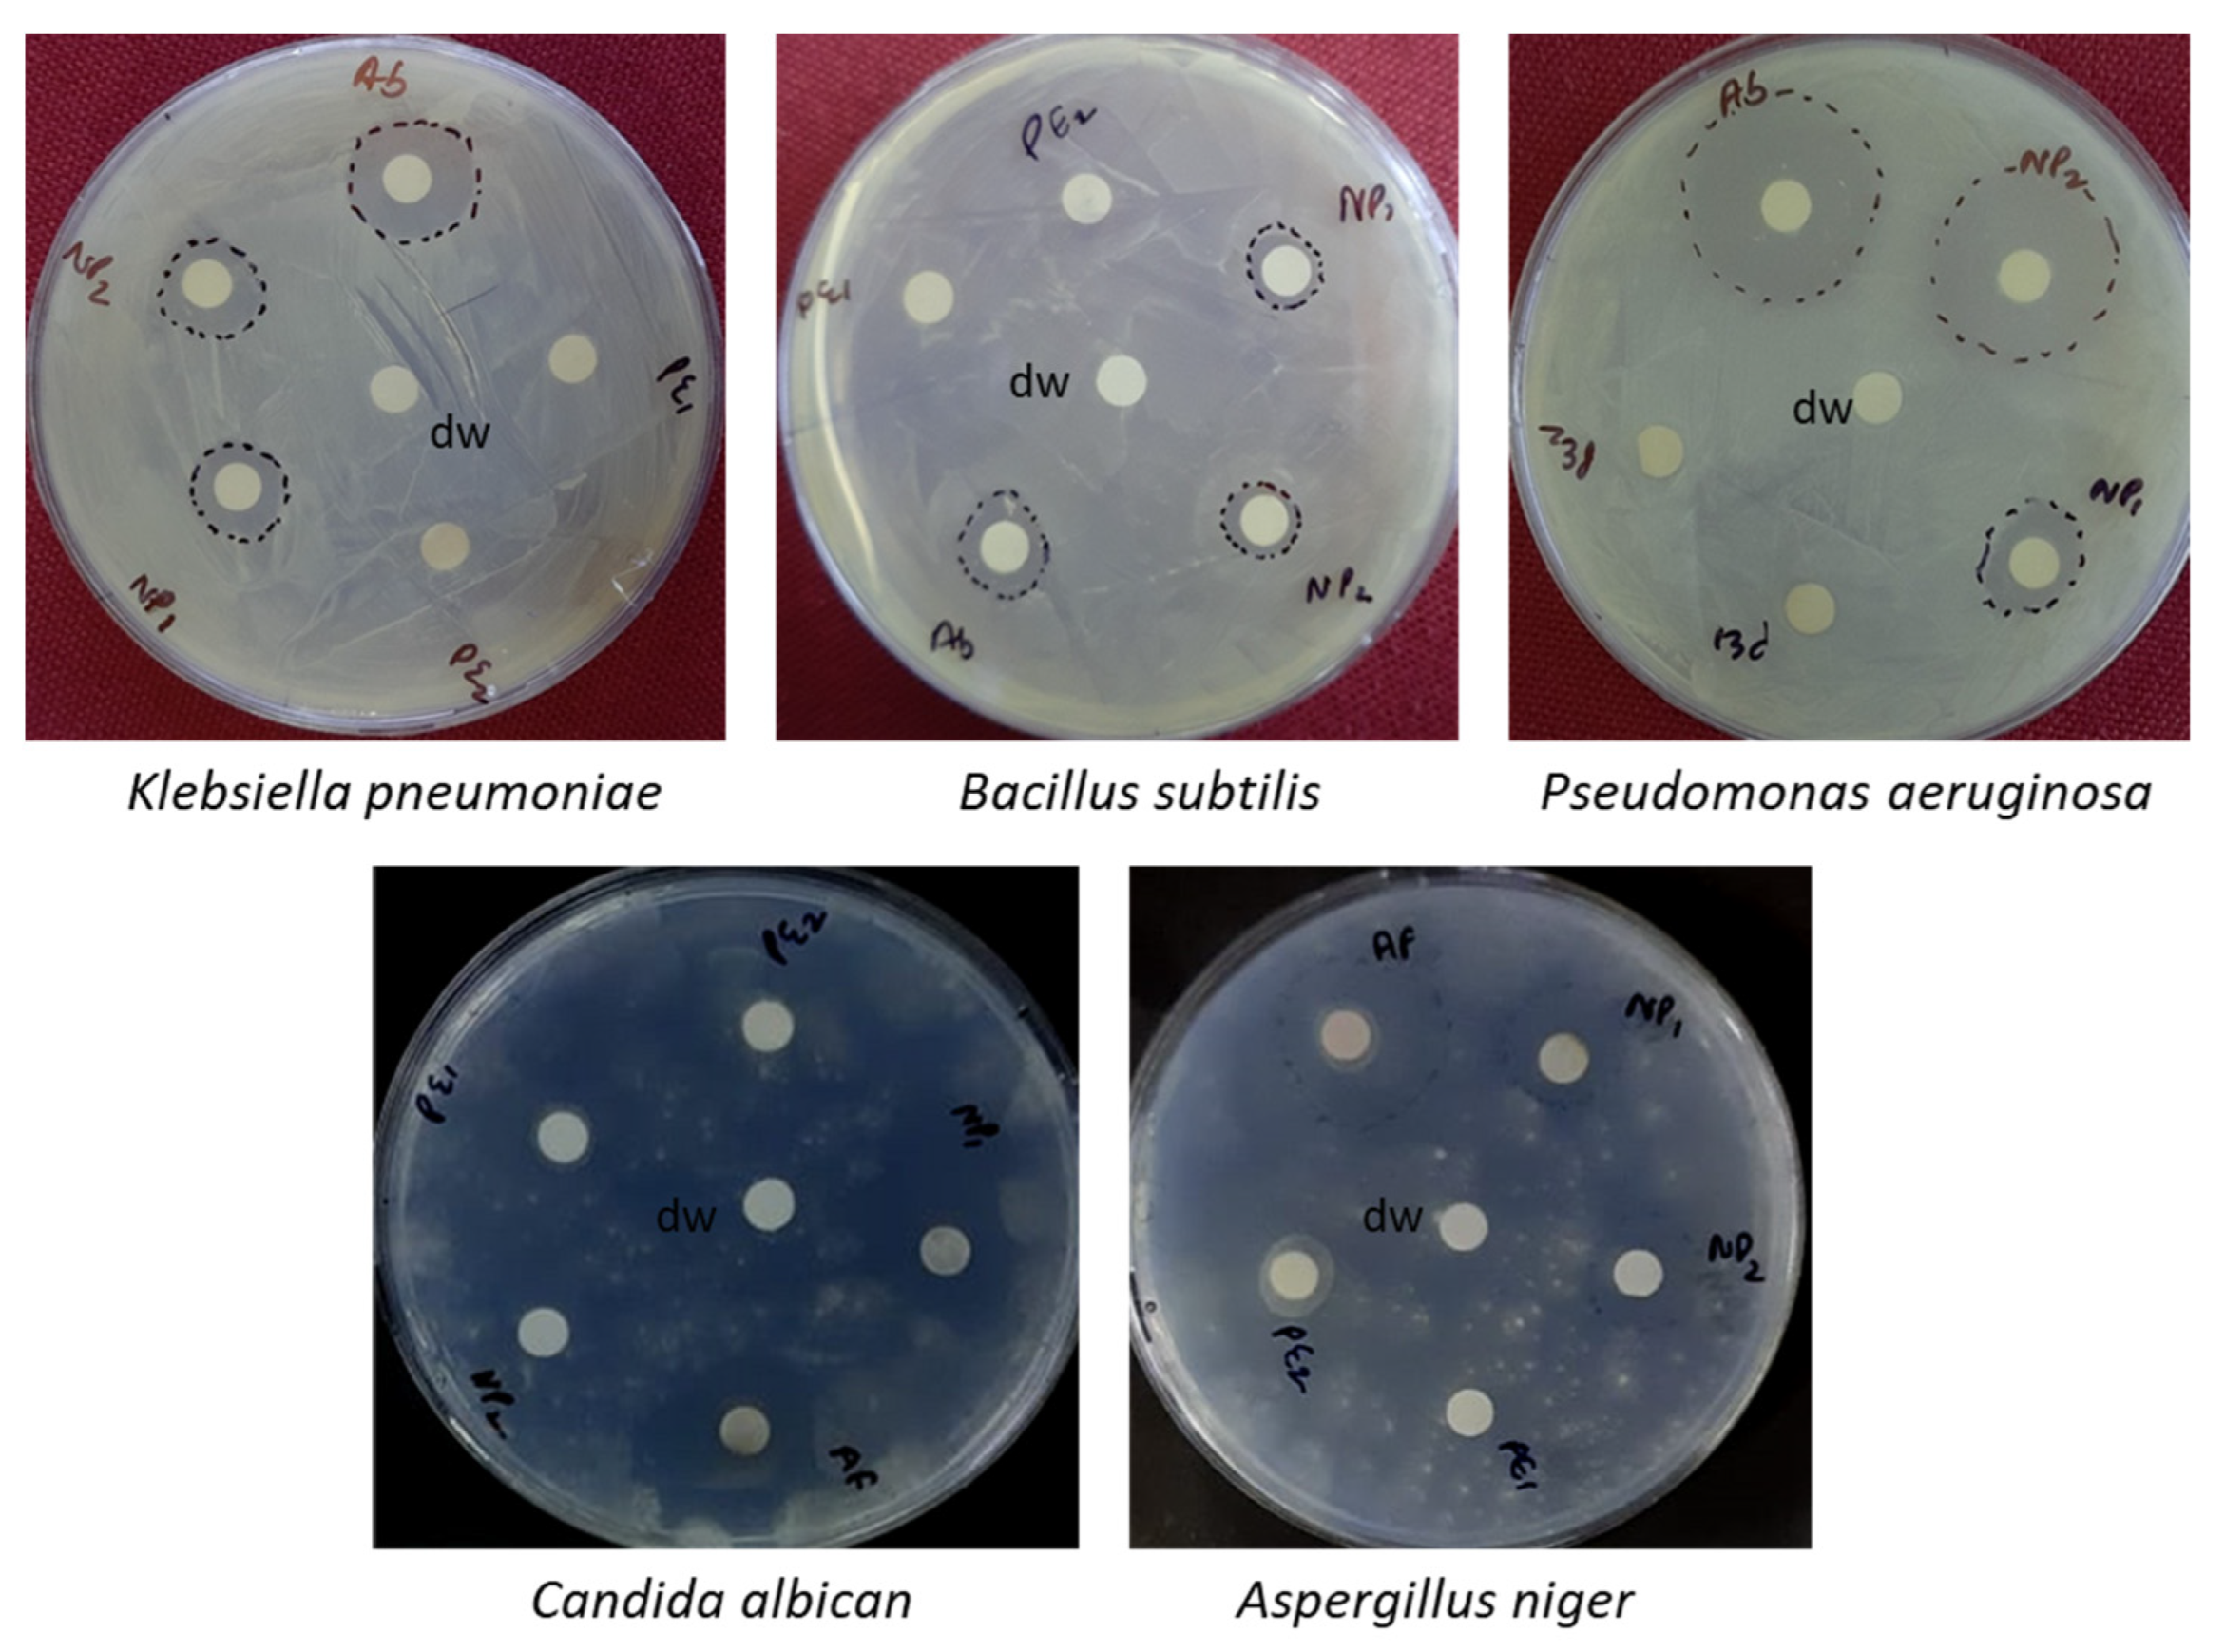
Sustainability 15 08911 g013

Potential of Biosynthesized Silver and Zinc Oxide Nanoparticles from Carissa opaca Extracts for Antimicrobial Activity and Wastewater Treatment
Abstract
1. Introduction
2. Material and Methods
2.1. Collection of Plant Material
2.2. Preparation of Plant Extract
2.3. Biosynthesis of Silver (AgNPs) and Zinc Oxide (ZnONPs) Nanoparticles
2.4. Antimicrobial Activity of Biosynthesized Silver and Zinc Oxide Nanoparticles
2.5. Photocatalytic Dye Degradation on Methylene Blue Dye
2.6. Characterization of Green Synthesised Nanoparticles
2.6.1. UV-Visible Spectroscopy
2.6.2. Fourier-Transform Infrared Spectroscopy (FTIR)
2.6.3. Scanning Electron Microscopy (SEM) and Energy Dispersive X-ray Spectroscopy (EDS)
2.6.4. X-Ray Diffraction (XRD)
2.6.5. Inductively Coupled Plasma Optical Emission Spectroscopy (ICP-OES)
2.6.6. High Resolution Transmission Electron Microscopy (HR-TEM)
3. Result and Discussion
3.1. Visual Observation
3.2. UV-VIS Spectrophotometer
3.3. FTIR
3.4. Inductively Coupled Plasma Optical Emission Spectrometery
3.5. SEM-EDX
3.6. High Resolution Transmission Electron Microscopy (HRTEM)
3.7. X-ray Diffraction (XRD)
3.8. Antibacterial and Antifungal Activity
3.9. Photocatalytic Dye Degradation of Methylene Blue
4. Conclusions
5. Future Aspects
Author Contributions
Funding
Institutional Review Board Statement
Informed Consent Statement
Data Availability Statement
Acknowledgments
Conflicts of Interest
References
- Shah, M.; Fawcett, D.; Sharma, S.; Tripathy, S.K.; Poinern, G.E.J. Green synthesis of metallic nanoparticles via biological entities. Materials 2015, 8, 7278–7308. [Google Scholar] [CrossRef]
- Kharissova, O.V.; Dias, H.R.; Kharisov, B.I.; Pérez, B.O.; Pérez, V.M.J. The greener synthesis of nanoparticles. Trends Biotechnol. 2013, 31, 240–248. [Google Scholar] [CrossRef]
- Shaik, M.R.; Khan, M.; Kuniyil, M.; Al-Warthan, A.; Alkhathlan, H.Z.; Siddiqui, M.R.H.; Adil, S.F. Plant-extract-assisted green synthesis of silver nanoparticles using Origanum vulgare L. extract and their microbicidal activities. Sustainability 2018, 10, 913. [Google Scholar] [CrossRef]
- Ishak, N.M.; Kamarudin, S.; Timmiati, S. Green synthesis of metal and metal oxide nanoparticles via plant extracts: An overview. Mater. Res. Express 2019, 6, 112004. [Google Scholar] [CrossRef]
- Roy, S.; Das, T.K. Plant mediated green synthesis of silver nanoparticles-A. Int. J. Plant Biol. Res. 2015, 3, 1044–1055. [Google Scholar]
- Bhushan, I.; Sharma, M.; Mehta, M.; Badyal, S.; Sharma, V.; Sharma, I.; Sistla, S. Bioactive compounds and probiotics—A ray of hope in COVID-19 management. Food Sci. Hum. Wellness 2021, 10, 131–140. [Google Scholar] [CrossRef]
- Marslin, G.; Siram, K.; Maqbool, Q.; Selvakesavan, R.K.; Kruszka, D.; Kachlicki, P.; Franklin, G. Secondary metabolites in the green synthesis of metallic nanoparticles. Materials 2018, 11, 940. [Google Scholar] [CrossRef]
- Rajeshkumar, S.; Bharath, L. Mechanism of plant-mediated synthesis of silver nanoparticles—A review on biomolecules involved, characterisation and antibacterial activity. Chem. Biol. Interact. 2017, 273, 219–227. [Google Scholar] [CrossRef]
- Singh, M.; Singh, S.; Prasad, S.; Gambhir, I.S. Nanotechnology in medicine and antibacterial effect of silver nanoparticles. Dig. J. Nanomater. Biostruct. 2008, 3, 115–122. [Google Scholar]
- Pérez-Díaz, M.A.; Boegli, L.; James, G.; Velasquillo, C.; Sánchez-Sánchez, R.; Martínez-Martínez, R.E.; Martinez-Gutierrez, F. Silver nanoparticles with antimicrobial activities against Streptococcus mutans and their cytotoxic effect. Mater. Sci. Eng. C 2015, 55, 360–366. [Google Scholar] [CrossRef]
- Kumar, R.; Howdle, S.; Münstedt, H. Polyamide/silver antimicrobials: Effect of filler types on the silver ion release. J. Biomed. Mater. Res. Part B Appl. Biomater. J. Soc. Biomater. Jpn. Soc. Biomater. Aust. Soc. Biomater. Korean Soc. Biomater. 2005, 75, 311–319. [Google Scholar] [CrossRef] [PubMed]
- Corrêa, J.M.; Mori, M.; Sanches, H.L.; Cruz, A.D.D.; Poiate, E.; Poiate, I.A.V.P. Silver nanoparticles in dental biomaterials. Int. J. Biomater. 2015, 2015, 485275. [Google Scholar] [CrossRef] [PubMed]
- Jain, J.; Arora, S.; Rajwade, J.M.; Omray, P.; Khandelwal, S.; Paknikar, K.M. Silver nanoparticles in therapeutics: Development of an antimicrobial gel formulation for topical use. Mol. Pharm. 2009, 6, 1388–1401. [Google Scholar] [CrossRef] [PubMed]
- Zhang, H. Application of Silver Nanoparticles in Drinking Water Purification; ProQuest; University of Rhode Island: Rhode Island, NY, USA, 2013. [Google Scholar]
- Durán, N.; Durán, M.; De Jesus, M.B.; Seabra, A.B.; Fávaro, W.J.; Nakazato, G. Silver nanoparticles: A new view on mechanistic aspects on antimicrobial activity. Nanomed. Nanotechnol. Biol. Med. 2016, 12, 789–799. [Google Scholar] [CrossRef] [PubMed]
- Abkhoo, J.; Panjehkeh, N. Evaluation of antifungal activity of silver nanoparticles on Fusarium oxysporum. Int. J. Infect. 2017, 4, e41126. [Google Scholar]
- Yassin, M.A.; Elgorban, A.M.; El-Samawaty, A.E.R.M.; Almunqedhi, B.M. Biosynthesis of silver nanoparticles using Penicillium verrucosum and analysis of their antifungal activity. Saudi J. Biol. Sci. 2021, 28, 2123–2127. [Google Scholar] [CrossRef]
- Bamal, D.; Singh, A.; Chaudhary, G.; Kumar, M.; Singh, M.; Rani, N.; Sehrawat, A.R. Silver nanoparticles biosynthesis, characterization, antimicrobial activities, applications, cytotoxicity and safety issues: An updated review. Nanomaterials 2021, 11, 2086. [Google Scholar] [CrossRef]
- Bouzekri, O.; El Gamouz, S.; Ed-Dra, A.; Moussout, H.; Dehmani, Y.; Ziyat, H.; Abouarnadasse, S. Green Synthesis of Nickel and Copper Nanoparticles Doped with Silver from Hammada scoparia Leaf Extract and Evaluation of Their Potential to Inhibit Microorganisms and to Remove Dyes from Aqueous Solutions. Sustainability 2023, 15, 1541. [Google Scholar] [CrossRef]
- Agnihotri, S.; Sillu, D.; Sharma, G.; Arya, R.K. Photocatalytic and antibacterial potential of silver nanoparticles derived from pineapple waste: Process optimization and modeling kinetics for dye removal. Appl. Nanosci. 2018, 8, 2077–2092. [Google Scholar] [CrossRef]
- Khatoon, N.; Mishra, A.; Alam, H.; Manzoor, N.; Sardar, M. Biosynthesis, characterization, and antifungal activity of the silver nanoparticles against pathogenic Candida species. BioNanoScience 2015, 5, 65–74. [Google Scholar] [CrossRef]
- Awwad, A.M.; Salem, N.M.; Abdeen, A.O. Biosynthesis of silver nanoparticles using Olea europaea leaves extract and its antibacterial activity. Nanosci. Nanotechnol. 2012, 2, 164–170. [Google Scholar] [CrossRef]
- Kourmouli, A.; Valenti, M.; van Rijn, E.; Beaumont, H.J.; Kalantzi, O.I.; Schmidt-Ott, A.; Biskos, G. Can disc diffusion susceptibility tests assess the antimicrobial activity of engineered nanoparticles? J. Nanoparticle Res. 2018, 20, 62. [Google Scholar] [CrossRef]
- Singh, A.; Gautam, P.K.; Verma, A.; Singh, V.; Shivapriya, P.M.; Shivalkar, S.; Samanta, S.K. Green synthesis of metallic nanoparticles as effective alternatives to treat antibiotics resistant bacterial infections: A review. Biotechnol. Rep. 2020, 25, e00427. [Google Scholar] [CrossRef] [PubMed]
- Lade, B.D.; Shanware, A.S. Phytonanofabrication: Methodology and Factors Affecting Biosynthesis of Nanoparticles. In Smart Nanosystems for Biomedicine, Optoelectronics and Catalysis; IntechOpen: London, UK, 2020. [Google Scholar]
- Shankar, S.S.; Ahmad, A.; Sastry, M. Geranium leaf assisted biosynthesis of silver nanoparticles. Biotechnol. Prog. 2003, 19, 1627–1631. [Google Scholar] [CrossRef] [PubMed]
- Dobrucka, R.; Długaszewska, J. Biosynthesis and antibacterial activity of ZnO nanoparticles using Trifolium pratense flower extract. Saudi J. Biol. Sci. 2016, 23, 517–523. [Google Scholar] [CrossRef]
- Ghojavand, S.; Madani, M.; Karimi, J. Green synthesis, characterization and antifungal activity of silver nanoparticles using stems and flowers of felty germander. J. Inorg. Organomet. Polym. Mater. 2020, 30, 2987–2997. [Google Scholar] [CrossRef]
- Jomehzadeh, N.; Koolivand, Z.; Dahdouh, E.; Akbari, A.; Zahedi, A.; Chamkouri, N. Investigating in-vitro antimicrobial activity, biosynthesis, and characterization of silver nanoparticles, zinc oxide nanoparticles, and silver-zinc oxide nanocomposites using Pistacia Atlantica Resin. Mater. Today Commun. 2021, 27, 102457. [Google Scholar] [CrossRef]
- Amargeetha, A.; Velavan, S. X-ray diffraction (XRD) and energy dispersive spectroscopy (EDS) analysis of silver nanoparticles synthesized from Erythrina indica flowers. Nanosci. Technol.Open Access 2018, 5, 1–5. [Google Scholar]
- Kailasa, S.K.; Park, T.J.; Rohit, J.V.; Koduru, J.R. Antimicrobial activity of silver nanoparticles. In Nanoparticles in Pharmacotherapy; Elsevier: Amsterdam, The Netherlands, 2019; pp. 461–484. [Google Scholar]
- Gomaa, E.Z. Silver nanoparticles as an antimicrobial agent: A case study on Staphylococcus aureus and Escherichia coli as models for Gram-positive and Gram-negative bacteria. J. Gen. Appl. Microbiol. 2017, 63, 36–43. [Google Scholar] [CrossRef]
- Pareek, V.; Devineau, S.; Sivasankaran, S.K.; Bhargava, A.; Panwar, J.; Srikumar, S.; Fanning, S. Silver nanoparticles induce a triclosan-like antibacterial action mechanism in multi-drug resistant Klebsiella pneumoniae. Front. Microbiol. 2021, 12, 638640. [Google Scholar] [CrossRef]
- Patra, J.K.; Baek, K.-H. Antibacterial activity and synergistic antibacterial potential of biosynthesized silver nanoparticles against foodborne pathogenic bacteria along with its anticandidal and antioxidant effects. Front. Microbiol. 2017, 8, 167. [Google Scholar] [CrossRef]
- Roberson, M.; Rangari, V.; Jeelani, S.; Samuel, T.; Yates, C. Synthesis and characterization silver, zinc oxide and hybrid silver/zinc oxide nanoparticles for antimicrobial applications. Nano Life 2014, 4, 1440003. [Google Scholar] [CrossRef]
- Elumalai, K.; Velmurugan, S. Green synthesis, characterization and antimicrobial activities of zinc oxide nanoparticles from the leaf extract of Azadirachta indica (L.). Appl. Surf. Sci. 2015, 345, 329–336. [Google Scholar] [CrossRef]
- Sirelkhatim, A.; Mahmud, S.; Seeni, A.; Kaus, N.H.M.; Ann, L.C.; Bakhori, S.K.M.; Mohamad, D. Review on zinc oxide nanoparticles: Antibacterial activity and toxicity mechanism. Nano Micro Lett. 2015, 7, 219–242. [Google Scholar] [CrossRef]
- Chen, X.; Zheng, Z.; Ke, X.; Jaatinen, E.; Xie, T.; Wang, D.; Zhu, H. Supported silver nanoparticles as photocatalysts under ultraviolet and visible light irradiation. Green Chem. 2010, 12, 414–419. [Google Scholar] [CrossRef]
- Singh, J.; Dhaliwal, A. Plasmon-induced photocatalytic degradation of methylene blue dye using biosynthesized silver nanoparticles as photocatalyst. Environ. Technol. 2018, 41, 1520–1534. [Google Scholar] [CrossRef]

| Sample | Cell Parameters | Crystalline Size (nm) | ||
|---|---|---|---|---|
| A | C | Vol (Å) | ||
| AgNPs (leaf) | 4.08 | - | 67.91 | 19.07 |
| AgNPs (stem) | 4.09 | - | 68.41 | 21.57 |
| ZnONPs (leaf) | 3.24 | 5.19 | 66.68 | 12.1 |
| ZnONPs (stem) | 3.24 | 5.19 | 66.68 | 12.5 |
Disclaimer/Publisher’s Note: The statements, opinions and data contained in all publications are solely those of the individual author(s) and contributor(s) and not of MDPI and/or the editor(s). MDPI and/or the editor(s) disclaim responsibility for any injury to people or property resulting from any ideas, methods, instructions or products referred to in the content. |
© 2023 by the authors. Licensee MDPI, Basel, Switzerland. This article is an open access article distributed under the terms and conditions of the Creative Commons Attribution (CC BY) license (https://creativecommons.org/licenses/by/4.0/).
Share and Cite
Mehta, M.; Chopra, C.; Sistla, S.; Bhushan, I. Potential of Biosynthesized Silver and Zinc Oxide Nanoparticles from Carissa opaca Extracts for Antimicrobial Activity and Wastewater Treatment. Sustainability 2023, 15, 8911. https://doi.org/10.3390/su15118911
Mehta M, Chopra C, Sistla S, Bhushan I. Potential of Biosynthesized Silver and Zinc Oxide Nanoparticles from Carissa opaca Extracts for Antimicrobial Activity and Wastewater Treatment. Sustainability. 2023; 15(11):8911. https://doi.org/10.3390/su15118911
Chicago/Turabian StyleMehta, Malvika, Chitrakshi Chopra, Srinivas Sistla, and Indu Bhushan. 2023. "Potential of Biosynthesized Silver and Zinc Oxide Nanoparticles from Carissa opaca Extracts for Antimicrobial Activity and Wastewater Treatment" Sustainability 15, no. 11: 8911. https://doi.org/10.3390/su15118911
APA StyleMehta, M., Chopra, C., Sistla, S., & Bhushan, I. (2023). Potential of Biosynthesized Silver and Zinc Oxide Nanoparticles from Carissa opaca Extracts for Antimicrobial Activity and Wastewater Treatment. Sustainability, 15(11), 8911. https://doi.org/10.3390/su15118911

